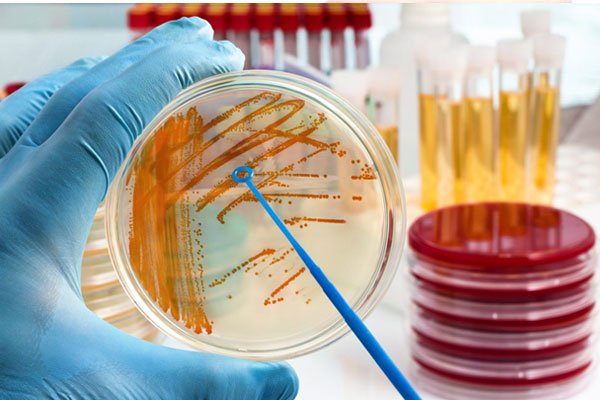
کشت ادرار چیست

آزمایش های لازم در بارداری
برخی از آزمایشات آزمایشگاهی بخشی از مراقبت های معمول در دوران بارداری هستند. برخی از این آزمایشات با نمونه خون انجام می شود. برخی دیگر از نمونه ادرار یا نمونه مایع گرفته شده از واژن، دهانه رحم یا راست روده استفاده می کنند. این آزمایشات می تواند به یافتن شرایطی کمک کند که ممکن است خطر عوارض را برای مادر و جنین افزایش دهد. بسیاری از مشکلاتی که توسط این آزمایشات پیدا می شوند در دوران بارداری قابل درمان هستند.

چه آزمایشاتی در اوایل بارداری انجام می شود؟
چندین آزمایش معمول در اوایل بارداری انجام می شود، از جمله:
-شمارش کامل خون (CBC)
-گروه خونی و فاکتور Rh
-آزمایش ادرار
-کشت ادرار
همچنین، زنان باردار معمولاً برای بیماریها و عفونتهای خاص در اوایل بارداری آزمایش میشوند، از جمله:
-سرخجه
-هپاتیت B و هپاتیت C
-ویروس نقص ایمنی انسانی (HIV)
-سایر عفونت های مقاربتی (STIs)
-سیفلیس

آزمایش شمارش کامل خون یا سی بی سی برای چیست؟
CBC تعداد انواع مختلف سلولهایی را که خون شما را میسازند، شمارش میکند. تعداد گلبول های قرمز خون می تواند نشان دهد که آیا نوع خاصی از کم خونی دارید یا خیر. تعداد گلبول های سفید خون می تواند نشان دهد که چند سلول مبارزه کننده با بیماری در خون شما وجود دارد. تعداد پلاکت ها می تواند نشان دهد که آیا مشکل لخته شدن خون دارید یا خیر.
آیا از نظر گروه خونی آزمایش انجام می شود؟
بله، در سه ماهه اول بارداری برای تعیین گروه خونی مادر باردار، مانند نوع A یا B یا o، آزمایش خون انجام می شود. همچنین، نمونه خون از نظر فاکتور Rh آزمایش می شود که مثبت یا منفی بودن آن مشخص شود.
فاکتور Rh، چیست؟
فاکتور Rh پروتئینی است که در سطح گلبول های قرمز یافت می شود. اگر سلول های خونی فرد دارای این پروتئین باشد، یعنی Rh او مثبت است. اما اگر سلول های خونی این پروتئین را نداشته باشد، Rh منفی می شود. قسمت "مثبت" یا "منفی" گروه خونی، مانند O مثبت یا A منفی، به وضعیت Rh خون اشاره دارد.

چرا مهم است که وضعیت Rh خون مشخص باشد؟
اگر مادر Rh منفی و جنین Rh مثبت باشد، بدن مادر می تواند آنتی بادی هایی علیه فاکتور Rh بسازد. این آنتی بادی ها می توانند به گلبول های قرمز جنین آسیب برسانند. این معمولاً در بارداری اول به دلیل اینکه فقط تعداد کمی آنتی بادی تولید می شود مشکلی ایجاد نمی کند. اما میتواند باعث مشکلات جدی در بارداری بعدی شود، از جمله مردهزایی.

اگر مادر Rh منفی باشد چه اتفاقی می افتد؟
اگر مادر باردار Rh منفی باشد، ممکن است در دوران بارداری به ایشان دارویی داده شود تا از ایجاد آنتی بادی های Rh جلوگیری شود. اگر مادر باردار Rh منفی باشد و قبلاً بدن ایشان تعداد مشخصی آنتی بادی Rh ساخته باشد مثلا در بارداری اول و دریافت نکردن دارو و یا تزریق خون در شرایط اورژانسی و صحرایی با شرایط خاص، ممکن است نیاز به آزمایشات و نظارت ویژه در طول بارداری داشته باشد و ناسازگاری ار هاش (ناسازگاری RH) ایجاد می شود. ممکن است نوزاد پس از تولد نیز به درمان نیاز داشته باشد.
آزمایش ادرار چیست؟
آزمایش ادرار یک آزمایش سریع آنالیز ادرار است:
گلبول های قرمز، نشانه احتمالی بیماری دستگاه ادراری مثل سنگ کلیه
گلبول های سفید، نشانه احتمالی عفونت دستگاه ادراری (UTI)
گلوکز، وجود آن می تواند نشانه دیابت باشد
این آزمایش همچنین میزان پروتئین دفع شده در ادرار را اندازه گیری می کند که می تواند با سطوح بعدی در بارداری مقایسه شود. سطوح بالای پروتئین ادرار ممکن است نشانه بیماری کلیوی یا پره اکلامپسی باشد، یک عارضه جدی که می تواند در اواخر بارداری یا پس از تولد نوزاد رخ دهد.
با رزرو وقت فوری از متخصص زنان متبحر در صورت داشتن علائم و نشانه های آزمایشگاهی این اختلال در تشخیص زودهنگام آن به خود و جنینتان کمک کنید.

کشت ادرار چیست؟
این آزمایش به دنبال کشف باکتری در ادرار شما است که می تواند نشانه عفونت ادراری باشد. این آزمایش به این دلیل انجام می شود که گاهی عفونت های ادراری بخصوص در بارداری علائمی ایجاد نمی کنند.
ممکن است چندین روز طول بکشد تا نتایج این آزمایش آماده شود. اگر آزمایش باکتری را در ادرار نشان دهد، باید با آنتی بیوتیک درمان انجام شود. پس از اتمام درمان، ممکن است یک آزمایش مجدد درخواست شود تا ببینند آیا باکتری ها از بین رفته اند یا خیر
چرا آزمایش سرخجه انجام می شود؟
سرخجه (گاهی اوقات سرخک آلمانی نیز نامیده می شود) در صورت ابتلا در دوران بارداری می تواند باعث نقص مادرزادی در جنین شود. آزمایش خون می تواند نشان دهد که آیا مادر به سرخجه مبتلا شده است یا در برابر این بیماری واکسینه شده و یا اینکه ابتلا نداشته و واکسن نیز دریافت نکرده است. اگر قبلا این عفونت را گرفته باشد یا علیه سرخجه واکسینه شده باشد، در مقابل این بیماری مصون هستند.
اگر مادر باردار در برابر سرخجه مصون نباشد چه اتفاقی می افتد؟
سرخجه به راحتی قابل انتقال است. اگر آزمایش خون نشان داد که مادر باردار ایمنی ندارد، باید از افرادی که در اطراف او در دوران بارداریش به این بیماری مبتلا هستند اجتناب کند.
یک واکسن وجود دارد، اما حاوی ویروس زنده است و در دوران بارداری توصیه نمی شود و تزریق نمی شود. اگر مادر باردار واکسینه نشده باشد، می تواند این واکسن را که شامل سرخک، اوریون، سرخجه (MMR) است را پس از تولد نوزاد دریافت کنید.

هپاتیت چیست؟
هپاتیت ویروسی است که کبد را آلوده می کند. اگر خانمی باردار باشد و همزمان به هپاتیت B یا C مبتلا باشد، می تواند این ویروس را به جنین خود منتقل کند. همه خانم های باردار باید از نظر عفونت هپاتیت B و هپاتیت C در دوران بارداری آزمایش شوند و چه بهتر که این بررسی قبل بارداری انجام شود.
اگر در دوران بارداری، مادری هپاتیت داشته باشد، چه اتفاقی می افتد؟

اگر مادر باردار به هپاتیت B یا هپاتیت C مبتلا باشد، ممکن است در دوران بارداری به مراقبت های ویژه نیاز داشته باشد. همچنین ممکن است کودک او پس از تولد نیز به مراقبت ویژه نیاز داشته باشد. اگر هر کدام از این عفونت ها وجود داشته باشد مادر بعد از زایمان می تواند به نوزاد خود شیر بدهد. واکسنی برای محافظت از نوزاد در برابر هپاتیت B در دسترس است. این واکسن به صورت سه دوز واکسن تزریق می شود که اولین دوز آن در عرض چند ساعت پس از تولد به نوزاد داده می شود.
چرا انجام آزمایش ایدز یا HIV مهم است؟
ویروس ایدز یا HIV به سلول های سیستم ایمنی بدن حمله می کند و در صورت عدم درمان باعث ایجاد سندرم نقص ایمنی اکتسابی (ایدز) می شود. اگر مادری HIV مثبت باشد، احتمال انتقال آن به جنین وجود دارد.
اگر تست HIV یا ایدز در بارداری مثبت باشد چه باید کرد؟
در حین بارداری نیز می توان از داروهایی استفاده کنید که می توانند خطر انتقال HIV را به جنین کاهش دهد. همچنین لازم است مادر باردار مراقبتهای تخصصی را تحت نظر متخصص عفونی و متخصص زنان خود (دکتر زنان) دریافت کند تا اطمینان حاصل شود که در طول بارداری تا حد امکان سالم بماند. به همین دلیل است که از همه افراد در اوایل بارداری آزمایش HIV می گیرند.هر چند که انجام این تست اختیاری می باشد ولی با توجه به اهمیت آن، از نظر علمی انجام این تست کاملا منطقی و کار درستی ست.

چه آزمایشات دیگری مربوط به عفونتهای منتقله از راه جنسی در طول بارداری انجام می شود؟
همه زنان در اوایل بارداری برای سیفلیس آزمایش می شوند. همچنین اگر زیر 25 سال سن دارند یا اگر در معرض خطر ابتلا به بیماری های مقاربتی هستند، باید از نظر کلامیدیا و سوزاک نیز آزمایش شوند.
این آزمایشات در اوایل بارداری انجام می شود زیرا این عفونت ها می توانند برای شما و جنین شما عوارض ایجاد کنند. آزمایشهای این عفونتها ممکن است بعداً در طول بارداری بر اساس سن و عوامل خطر مجدد تکرار شوند.
با مطالعه مقاله عفونتهای مقاربتی بیشتر با این بیماریها و راههای پیشگیری از آنها آشنا شوید.
اگر مادری در طول بارداری سیفلیس، کلامیدیا یا سوزاک داشته باشد چه اقدامی لازم است؟
اگر در طی بارداری مادری مبتلا به سیفلیس، کلامیدیا یا سوزاک باشد، باید در دوران بارداری تحت درمان قرار بگیرد و مجددا آزمایش دهد تا ببینند آیا درمان موثر بوده است یا خیر. شریک جنسی او نیز باید تحت درمان قرار گیرد تا از ابتلای مجدد او جلوگیری شود.
چه کسانی باید برای سل (TB) آزمایش شوند؟
افرادی که در معرض خطر بالای ابتلا به سل هستند باید برای آن آزمایش شوند. افراد در معرض خطر شامل افرادی هستند که مبتلا به HIV یا ایدز هستند، در تماس نزدیک با افرادی که مبتلا به سل هستند یا اهل کشوری با نرخ بالای سل هستند.
آزمایشاتی که در ماههای بالاتر بارداری انجام می شود
بعداً در طول بارداری چه آزمایشاتی انجام می شود؟
آزمایشاتی که در طول بارداری انجام می شود شامل غربالگری دیابت و غربالگری استرپتوکوک گروه B (GBS) است.
با مطالعه نکات مراقبتهای بارداری با کلیات این مراقبت ها آشنا شوید.
آزمایش غربالگری دیابت در بارداری چیست؟
این آزمایش سطح گلوکز یا قند خون را اندازه گیری می کند. سطح قند خون بالا ممکن است نشانه دیابت بارداری باشد که می تواند در دوران بارداری مشکلاتی ایجاد کند. برای این آزمایش، خانم باردار مخلوط قند مخصوصی را می نوشد. یک ساعت بعد نمونه خون گرفته می شود و به آزمایشگاه فرستاده می شود. اگر سطح قند خون بالا است، باید نوع دیگری از آزمایش گلوکز را برای تایید نتایج انجام دهد.

چه زمانی غربالگری دیابت انجام می شود؟
این آزمایش معمولا بین هفته های 24 تا 28 بارداری انجام می شود. اگر فاکتورهای خطر ابتلا به دیابت را داشته باشید یا در بارداری قبلی دیابت بارداری داشته باشید، ممکن است این آزمایش در سه ماهه اول بارداری انجام شود.
استرپتوکوک گروه B (GBS) چیست؟
GBS یکی از باکتری هایی است که در بدن زندگی می کند. معمولاً در بزرگسالان بیماری جدی ایجاد نمی کند و یک بیماری منتقله جنسی نیست.
چرا GBS در دوران بارداری نگران کننده است؟
در زنان، GBS اغلب در واژن و رکتوم یافت می شود. این بدان معنی است که GBS می تواند در طول زایمان از مادر به جنین منتقل شود. زمانی که مادر در حین زایمان تحت درمان با آنتی بیوتیک قرار نگیرد، برای 1 یا 2 نوزاد از 100 نوزاد اتفاق می افتد. زمانی که مادر تحت درمان قرار می گیرد، احتمال بیمار شدن نوزاد بسیار کمتر است.
چگونه GBS می تواند بر نوزاد تازه متولد شده تأثیر بگذارد؟
اگرچه به ندرت اتفاق می افتد که نوزادی به GBS مبتلا شود، اما در صورت وقوع می تواند بسیار جدی باشد. تعداد کمی از نوزادان مبتلا به GBS حتی با درمان فوری جان خود را از دست می دهند.
تست GBS چگونه انجام می شود؟
آزمون GBS بین هفته های 36 تا 38 بارداری انجام می شود. برای این آزمایش از یک سواب برای نمونه برداری از واژن و راست روده(رکتوم) استفاده می شود.
اگر نتایج نشان داد که GBS وجود دارد، پس از شروع دردهای زایمان، آنتی بیوتیک ها باید از طریق تزریق داخل وریدی (IV) داده شود. این کار برای محافظت از جنین در برابر عفونت انجام می شود. بهترین زمان برای درمان در زمان زایمان است.

آزمایش ژنتیک برای نقایص مادرزادی
اولین قدم برای غربالگری نقایص مادرزادی در دوران بارداری چیست؟
غربالگری برای نقایص مادرزادی با ارزیابی عوامل خطر شروع می شود. در اوایل بارداری، متخصص زنان و زایمان شما (ob-gyn) ممکن است لیستی از سوالات را به شما بدهد تا بفهمد آیا شما دارای عوامل خطر هستید یا خیر. اگر فاکتورهای خطر وجود داشته باشد، ممکن است بخواهید برای اطلاعات دقیق تر در مورد خطرات خود به یک مشاور ژنتیک مراجعه کنید.

چه عواملی خطر نقایص مادرزادی را افزایش می دهد؟
اکثر نوزادان دارای نقص مادرزادی از زوجین بدون عوامل خطر متولد می شوند. اما خطر نقایص مادرزادی در صورت وجود عوامل خاصی بیشتر است. عوامل خطر عبارتند از:
-داشتن سابقه شخصی یا خانوادگی نقایص مادرزادی
-متعلق به گروه های قومی خاص
-داشتن 35 سال یا بیشتر
-ابتلا به دیابت قبل از بارداری

با مطالعه مقاله نقایص مادرزادی با علل و عوامل ایجاد کننده و راههای پیشگیری از بیشتر آشنا شوید.
تفاوت بین غربالگری و آزمایش تشخیصی برای نقص مادرزادی چیست؟
هنگامی که آزمایشات غربالگری در دوران بارداری انجام می شود می تواند احتمال ابتلای جنین به برخی از نقایص معمول مادرزادی را بگوید. آزمایش غربالگری نمی تواند بگوید که آیا جنین واقعاً نقص مادرزادی دارد یا خیر فقط احتمال آن را تخمین میزند. هیچ خطری برای جنین در اثر آزمایش های غربالگری به وجود نمی آید.
آزمایشهای تشخیصی میتوانند بسیاری از نقصهای مادرزادی، اما نه همه آنها را، ناشی از نقص در ژن یا کروموزومها شناسایی کنند. میتوانید به جای آزمایشهای غربالگری یا علاوه بر آن، آزمایشهای تشخیصی دیگری طبق دستور و تشخیص متخصص زنان خود انجام دهید.

آیا لازم است در بارداری غربالگری یا آزمایش برای نقایص مادرزادی انجام شود؟
خیر، غربالگری و آزمایش ژنتیک یک انتخاب شخصی است. برخی از افراد ترجیح می دهند ندانند که آیا در معرض خطر تولد فرزندی با نقص مادرزادی هستند یا اینکه آیا فرزندشان نقص مادرزادی خواهد داشت. اما برخی دیگر می خواهند قبل از تولد فرزند خود از آن اطلاع داشته باشند.
اطلاع از قبل تولد و اوایل بارداری امکان تصمیم گیری برای عدم ادامه بارداری را برای زوجین فراهم می کند. اگر تصمیم به ادامه بارداری داشته باشند، اطلاع از قبل به آنها زمان میدهد تا برای داشتن فرزند مبتلا به اختلال آماده شوند. این بدان معنی است که می توانند مراقبت های پزشکی را که ممکن است فرزندشان به آن نیاز داشته باشد سازماندهی کنند.
برای تفسیر صحیح جواب غربالگری خود و در نهایت گرفتن تصمیم درست با متخصص زنان و زایمان یا مشاور ژنتیک خود در مورد نتایج آزمایش صحبت و مشورت کنید.

واژه نامه:
سندرم نقص ایمنی اکتسابی (ایدز): گروهی از علائم و نشانهها، معمولاً عفونتهای شدید، در فردی که ویروس نقص ایمنی انسانی (HIV) دارد.
کم خونی: سطوح پایین غیرطبیعی گلبول های قرمز در جریان خون. بیشتر موارد ناشی از کمبود آهن (کمبود آهن) است.
آنتی بیوتیک ها: داروهایی که انواع خاصی از عفونت ها را درمان می کنند.
آنتی بادی ها: پروتئین های موجود در خون که بدن در واکنش به مواد خارجی مانند باکتری ها و ویروس ها تولید می کند.
باکتری: موجودات تک سلولی که می توانند باعث عفونت در بدن انسان شوند.
نقایص مادرزادی: مشکلات جسمانی که در بدو تولد وجود دارند.
سلول ها: کوچکترین واحدهای ساختاری بدن.
دهانه رحم یا سرویکس: انتهای پایینی و باریک رحم در بالای واژن.
کلامیدیا: یک عفونت مقاربتی ناشی از باکتری. این عفونت می تواند منجر به بیماری التهابی لگن و ناباروری شود.
کروموزوم ها: ساختارهایی که در داخل هر سلول بدن قرار دارند. آنها حاوی ژن هایی هستند که آرایش فیزیکی افراد را تعیین می کنند.
عوارض: بیماری ها یا شرایطی که در نتیجه بیماری یا وضعیت دیگری رخ می دهد. به عنوان مثال، پنومونی است که در نتیجه آنفولانزا رخ می دهد. یک عارضه نیز می تواند در نتیجه شرایطی مانند بارداری رخ دهد. یک نمونه از عوارض بارداری، زایمان زودرس است.
دیابت شیرین: وضعیتی که در آن سطح قند خون افزایش می یابد.
جنین: مرحله رشد انسان بیش از 8 هفته تکمیل شده پس از لقاح.
ژن: بخشهایی از DNA که حاوی دستورالعملهایی برای رشد ویژگیهای فیزیکی فرد و کنترل فرآیندهای بدن است. ژن واحد اصلی وراثت است و می تواند از والدین به فرزند منتقل شود.
مشاور ژنتیک: یک متخصص مراقبت های بهداشتی با آموزش های ویژه در زمینه ژنتیک که می تواند مشاوره تخصصی در مورد اختلالات ژنتیکی و آزمایشات قبل از تولد ارائه دهد.
دیابت بارداری: دیابتی که در دوران بارداری ایجاد می شود.
گلوکز: قندی در خون که منبع اصلی سوخت بدن است.
سوزاک: یک عفونت مقاربتی که می تواند منجر به بیماری التهابی لگن، ناباروری و آرتریت شود.
استرپتوکوک گروه B (GBS): نوعی باکتری که بسیاری از افراد به طور طبیعی حامل آن هستند و می توانند در زمان زایمان به جنین منتقل شوند. GBS می تواند باعث عفونت جدی در برخی از نوزادان شود. آنتی بیوتیک ها در حین زایمان به زنان حامل باکتری برای جلوگیری از عفونت نوزاد داده می شود.
هپاتیت B: عفونت ناشی از یک ویروس که می تواند از طریق خون، مایع منی یا سایر مایعات بدن آلوده به ویروس منتشر شود.
هپاتیت C: عفونت ناشی از یک ویروس که می تواند از طریق خون آلوده منتقل شود.
ویروس نقص ایمنی انسانی (HIV): ویروسی که به سلول های خاصی از سیستم ایمنی بدن حمله می کند. در صورت عدم درمان، HIV می تواند باعث سندرم نقص ایمنی اکتسابی یا ایدز شود.
ایمنی: سیستم دفاعی بدن که فرد را در برابر بیماری های عفونی محافظت می کند.
واکسن سرخک، اوریون، سرخجه (MMR): واکسنی که برای محافظت در برابر سرخک، اوریون و سرخجه تجویز می شود. این واکسن حاوی ویروس های زنده ای است که تغییر کرده اند تا باعث بیماری نشوند. تزریق این واکسن برای زنان باردار ممنوع است.
پره اکلامپسی: اختلالی که می تواند در دوران بارداری یا بعد از زایمان که در آن فشار خون بالا و سایر علائم آسیب اندام وجود دارد، رخ دهد. این علائم شامل مقدار غیر طبیعی پروتئین در ادرار، تعداد کم پلاکت ها، عملکرد غیر طبیعی کلیه یا کبد، درد بالای شکم، وجود مایع در ریه ها، سردرد شدید یا تغییر در بینایی است.
رکتوم: آخرین قسمت دستگاه گوارش.
فاکتور Rh: پروتئینی که در سطح گلبول های قرمز یافت می شود.
سرخجه: ویروسی که در صورت آلوده شدن زن در دوران بارداری به جنین منتقل می شود. این ویروس می تواند باعث سقط جنین یا نقایص شدید مادرزادی شود.
عفونت های مقاربتی (STIs): عفونت هایی که از طریق تماس جنسی منتقل می شوند. عفونت ها عبارتند از کلامیدیا، سوزاک، ویروس پاپیلومای انسانی (HPV)، تبخال، سیفلیس، و ویروس نقص ایمنی انسانی (HIV) عامل سندرم نقص ایمنی اکتسابی یا ایدز
مرده زایی: تولد جنین مرده.
سیفلیس: یک عفونت مقاربتی (STI) که توسط ارگانیسمی به نام ترپونما پالیدوم ایجاد می شود. این عفونت ممکن است باعث مشکلات سلامتی بزرگ یا مرگ در مراحل بعدی شود.
سه ماهه: یک دوره 3 ماهه در بارداری. می تواند اول، دوم یا سوم باشد.
سل (TB): بیماری که ریه ها و سایر اندام های بدن را درگیر می کند. سل توسط باکتری ایجاد می شود.
عفونت دستگاه ادراری (UTI): عفونت در هر قسمت از سیستم ادراری از جمله کلیه ها، مثانه یا مجرای ادرار.
واژن: ساختاری لوله مانند که توسط ماهیچه ها احاطه شده است. واژن از رحم به خارج از بدن منتهی می شود وهمچنین مسیر ایجاد رابطه جنسی در زنان است.














